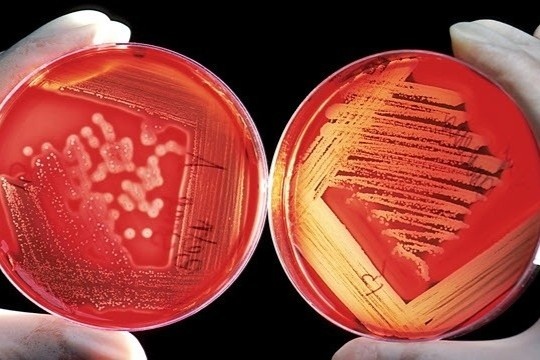

|
|
Các dị vật nam châm được lấy ra từ bụng bé trai. Ảnh: BVCC. |
Theo thông tin từ Bệnh viện Nhi đồng 2 (TP.HCM) ngày 14/3, đơn vị này vừa phẫu thuật lấy 20 viên nam châm trong dạ dày và ruột non của bé trai 10 tuổi.
Theo bác sĩ chuyên khoa I Nguyễn Hiền, khoa Ngoại Tổng hợp, 4 ngày trước khi nhập viện, bé liên tục nôn ói ra thức ăn, dịch màu xanh, vàng kèm theo đau bụng từng cơn và nhiều ngày chưa đi tiêu.
Tuy nhiên, người nhà cho biết bé có tiền sử bị bệnh tâm lý, ít nói và sinh hoạt bình thường nên không rõ thời điểm nuốt dị vật.
Qua bước đầu thăm khám, bác sĩ ghi nhận bé tỉnh, sinh hiệu ổn, phần bụng mềm, trướng nhẹ và ấn đau. Kết quả chụp X-quang phát hiện bụng bệnh nhi có 2 khối dị vật bên trong. Ngoài ra, quai ruột chứa nhiều khối nam châm, thành ruột bị viêm và thủng nhiều lỗ. Ngay lập tức, trẻ được chỉ định phẫu thuật lấy dị vật.
Sau ca mổ, các bác sĩ lấy ra tổng cộng 20 viên nam châm. Các dị vật nam châm có hình thù thuôn dài, hình trái tim và hình ngôi sao. Đây là lý do khiến bé lầm tưởng thành đây là viên kẹo.
Bên cạnh đó, phần hồi tràng (đoạn sau của hỗng tràng và tá tràng, chiếm khoảng 1/2 chiều dài dưới của ruột non) bị viêm thủng nhiều lỗ nên ê-kíp mổ đã cắt bỏ một đoạn khoảng 15 cm và làm hậu môn tạm.
Theo các bác sĩ Bệnh viện Nhi đồng 2, trường hợp trẻ nuốt nhầm dị vật và phải cắt bỏ đoạn ruột không hiếm. Trước đó, đơn vị này từng tiếp nhận bé gái 4 tuổi nuốt phải các viên bi xếp hình bằng nam châm. Hậu quả, bé bị thủng ruột do các viên bi này hít hai mép ruột lại với nhau.
Các bác sĩ khuyến cáo khi mua đồ chơi cho trẻ, phụ huynh cần chú ý chọn loại phù hợp với độ tuổi của con, tránh những thứ có kích thước nhỏ hay hình dạng dễ nhầm lẫn với thực phẩm để tránh xảy ra tai nạn đáng tiếc.
Bạn có hiểu đúng về thảo dược
Bằng những kiến thức khoa học, nhà thảo dược học Rosalee De La Forêt đã viết cuốn sách Năng lượng sống từ thảo dược để chia sẻ về tính năng bổ trợ sức khỏe từ thức ăn và gia vị hàng ngày. Bên cạnh đó, tác giả cũng đưa ra lời khuyên hữu ích để chế biến và tận hưởng các loại nguyên liệu này trong cuộc sống.